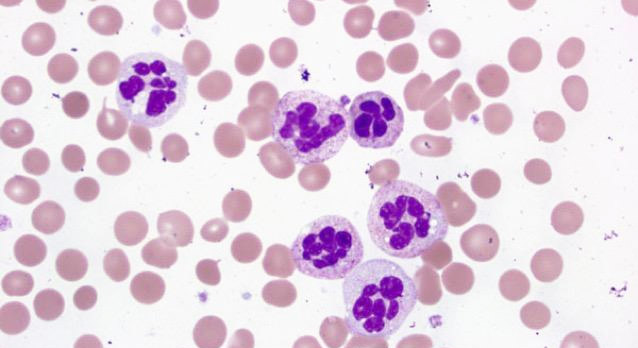
аномалії нейтрофілів

- Йога начинающим видео
- Хулахуп танец видео
- Смотреть моя тренировка видео
- Видео тренировки александра емельяненко
- Как правильно крутить обруч на бедрах видео
- Тренировки в кудо видео
- Тренировки рой джонса видео
- Йога онлайн смотреть видео
- Тренировки костя дзю видео
- Видео тренировки роя джонса
- Видео спинальной
- Айенгар йога видео
- Йога для женщин на видео
- Правильно крутить обруч видео
- Плиометрические отжимания видео
- Новости
Управление Здравоохранения Евпаторийского городского совета (С)2011
67 гостей
Нейтрофіли (NEUT): знижені, підвищені в крові, норма, у дітей
- Юні, молоді, палички, сегменти ...
- Після двох перекрестов норми зрівнюються
- Таблиця: норми у дітей нейтрофілів і інших лейкоцитів за віком
- Нейтрофіли і лімфоцити - співвідношення
- Від народження до зрілості
- Як вони працюють?
- Відео: нейтрофіл бореться з бактерією
- Завжди і всюди перші
- В яких випадках кількість нейтрофілів знижується?
- аномалії нейтрофілів
Автор: З. Неллі Володимирівна, лікар лабораторної діагностики НДІ трансфузіології та медичних біотехнологій
Нейтрофіли (NEUT) серед всіх білих клітин крові займають особливе становище, вони, зважаючи на свою чисельність, очолюють список всього лейкоцитарного ланки і гранулоцитарного ряду - окремо.
Без нейтрофілів не обходиться жоден запальний процес, тому що їх гранули наповнені бактерицидними речовинами, їх мембрани несуть рецептори до імуноглобулінів класу G (IgG), що дозволяє їм пов'язувати антитіла даної специфічності. Мабуть, головною корисною рисою нейтрофілів є їх висока здатність до фагоцитозу, нейтрофіли першими приходять в запальний вогнище і тут же приступають до ліквідації "аварії" - одна єдина нейтрофильная клітинка здатна враз поглинути 20-30 загрожують здоров'ю людини бактерій.
Юні, молоді, палички, сегменти ...
Норма нейтрофілів в Загалом аналізі крові дорослої людини в процентному відношенні складає 45-70% (1-5% паличкоядерних + 60-65% сегментоядерних), однак щоб ясніше було картини зручніше використовувати більш інформативне значення - абсолютний вміст нейтрофілів. У нормі в периферичної крові дорослої людини їх налічують від 2,0 до 5,5 Гіга / літр.
До речі, років 40 назад норми білих клітин крові, в тому числі і нейтрофілів, були дещо інші, але підвищений радіаційний фон і інші екологічні чинники зробили свою справу.
Можливо, розглядаючи бланк загального аналізу крові, читач помітив, що графа «нейтрофіли» розділена на 4 частини:
- Мієлоцити, яких в нормі бути не повинно (0%);
- Юні - можуть випадково «затесатися» і в нормі (0-1%);
- Палички: їх небагато - 1-5%;
- Сегменти, що становлять основну масу нейтрофілів (45-70%).
Незрілі нейтрофіли (метамієлоцити або юні) в периферичну кров при нормальних станах не прагнуть, вони разом з Мієлоцити залишаються в кістковому мозку і створюють резерв, але якщо і виявляються в кровотоці, то лише в одиничних екземплярах. Підвищені значення даного показника, тобто, поява молодих форм в крові в неприпустимих кількостях (зрушення вліво) вказує на серйозні порушення здоров'я ( лейкози , Важкі інфекційно-запальні процеси).

Молоді клітини (незрілі гранулоцити) при розгляді під мікроскопом відрізняються від зрілих сегментоядерних лейкоцитів формою ядра (пухка соковита «підкова» у юних). Палички (паличкоядерні лейкоцити - не зовсім дозріли форми) мають ядро, схоже на вигнутий джгут (звідси і назва).
Підвищені або високі рівні нейтрофілів (вище 5,5 х10 Г / л) називають нейтрофільозом (нейтрофільний лейкоцитоз ). За знижені або низькі кількості нейтрофільних лейкоцитів приймають число клітин менше, ніж 2,0 х 10Г / л - це нейтропенія. І те, і інше стан має свої причини, які будуть розглянуті трохи пізніше.
Після двох перекрестов норми зрівнюються
Лейкоцитарна формула дітей (особливо маленьких) помітно відрізняється від такої у дорослих. Все це пояснюється зміною співвідношення лімфоцитів і нейтрофілів від народження і до 14-15-річного віку.

Багато хто чув, що у дітей бувають якісь перехрещення (якщо накреслити графік) і ось, що все це означає:
- У новонародженої дитини, який тільки з'явився на світло, кількість нейтрофілів знаходиться десь в межах 50-72%, а лімфоцитів - близько 15-34%, проте число нейтрофілів в перші години життя продовжує наростати. Потім (не проходить і доби) популяція нейтрофільних лейкоцитів різко змінює напрямок в зворотну сторону і починає знижуватися, лімфоцити, при цьому, рухаються їй назустріч, тобто, підвищуються. В якийсь момент, зазвичай це відбувається між 3 і 5 днем життя, числа цих клітин зрівнюються, і криві на графіку перетинаються - це і є перший перехрест. Після перехрещення лімфоцити ще деякий час будуть підвищуватися, а нейтрофіли знижуватися (приблизно до кінця другого тижня життя), щоб знову повернути у зворотний бік.
- Через півмісяця ситуація знову змінюється: рівень лімфоцитів знижується, вміст нейтрофілів зростає, тільки цей процес йде вже не в такому швидкому темпі. Точки перетину ці клітини досягнутий, коли дитина буде збиратися в перший клас - це час другого перехрещення.
Таблиця: норми у дітей нейтрофілів і інших лейкоцитів за віком

Нейтрофіли і лімфоцити - співвідношення
Взагалі, нейтрофіли і лімфоцити не тільки у дитини, а й у дорослих людей знаходяться в певній залежності один від одного. Нейтрофіли відносяться до компонентів клітинного імунітету і першими виходять «на стежку війни» з чужорідними агентами - в аналізі крові лейкоцитоз за рахунок підвищених нейтрофілів, а лімфоцити в процентному відношенні в цей час знижені.

Нейтрофіли, виконавши свої функції, гинуть «на полі брані», перетворюючись в гній, а нові не встигають замінити їх. Згодом разом з іншими непотрібними продуктами (мікробами і зруйнованими тканинами), загиблі зернисті лейкоцити (нейтрофіли) будуть прибрані «двірниками організму» - моноцитами . Це не означає, що нейтрофіли повністю «відмовилися» брати участь в запальній відповіді, їх просто стало менше, до того ж в цей час в боротьбу включаються клітини центральної ланки імунної системи - лімфоцити (Т-популяція і антітелообразователі - В-клітини). Активно диференціюючись, вони збільшують своє загальне число, тобто, підвищуються, нейтрофіли в цей час, зрозуміло, знижені. У лейкоцитарній формулі це буде помітно дуже добре. З огляду на те, що зміст усіх клітин лейкоцитарного ланки становить 100%, підвищення нейтрофілів до 70 і більше відсотків, викличе зниження клітин агранулоцитарної ряду - лімфоцитів (їх число буде знижений - менше 30%). І навпаки: високі рівнілімфоцитів - низький вміст нейтрофілів. Коли всі гострі процеси, що вимагають мобілізації клітинного і гуморального імунітету, закінчуються, і ті, і інші клітини приходять в свою фізіологічну норму, про що говорить «спокійна» лейкоцитарна формула.
Від народження до зрілості
Свій життєвий цикл нейтрофіли починають в кістковому мозку від мієлобластів і, проходячи стадії проміелоціти, мієлоцитів, метамієлоцити (юні) доходять до клітини, здатної покинути місце народження. В аналізі крові вони представлені дозрівають формами - палочкоядерним лейкоцитами (передостання, 5 стадія розвитку нейтрофіла до сегментоядерних клітини, тому їх так мало в порівнянні з сегментами) і зрілими сегменто нейтрофилами.

Назва «палички» і «сегменти» нейтрофіли отримали через форми ядра: у паличок воно нагадує джгут, а у сегментів розділене на дольки (від 2 до 5 сегментів). Покинувши кістковий мозок як зрілої клітини, нейтрофіли поділяються на 2 частини: одна відправляється «у вільне плавання», щоб постійно спостерігати «що й до чого», інша йде в запас - прикріплюється до ендотелію і чекає свого часу (пристеночное стояння - готовність до виходу з посудини). Нейтрофіли, як і інші клітини лейкоцитарного ланки, виконують свої функції за межами судин, а кровоносне русло використовують лише як дорогу в осередок запалення, але якщо потрібно, резервний пул відреагує дуже швидко і відразу включиться в процес захисту.
Найбільша фагоцитарна активність характерна зрілим нейтрофилам, однак при важких інфекціях її все одно не вистачає, і тоді на допомогу зрілим циркулює клітинам, приходять «родичі» з резерву, які спокійно чекали в кістковому мозку у вигляді молодих форм (ті, які стояли, приліпившись до судинним стінок, пішли першими).
Однак може створюватися така ситуація, коли витрачені всі запаси, кістковий мозок працює, але не встигає забезпечити потреби в лейкоцитах, тоді в кров починають виходити молоді форми (юні) і навіть мієлоцитів, яких в нормі, як сказано вище, там ніяк бути не повинно . Іноді ці незрілі клітини, намагаючись поліпшити фінансове становище, виходять з кісткового мозку в великих кількостях, тому при серйозних патологічних процесах так помітно змінюється лейкоцитарна формула крові. Слід зазначити, що незрілі клітини, які покинули кістковий мозок, не в повній мірі придбали здатності зрілих повноцінних сегментоядерних нейтрофілів. Фагоцитарна активність метамиелоцитов ще досить висока (до 67%), у мієлоцитів вона вже не доходить до 50%, а у промиелоцитов активність фагоцитозу і зовсім низька - 10%.
Нейтрофіли рухаються, подібно амеба, а за рахунок цього вони, переміщуючись вздовж капілярних стінок, не тільки циркулюють в кровоносній руслі, але і (при необхідності) залишають кровоток, прямуючи в місця запалення.
Нейтрофіли - активні мікрофаги, в їх компетенцію, в основному, входить захоплення збудників гострих інфекцій, в той час як макрофаги, до яких відносяться моноцити і нерухомі гістіоцити, зайняті в фагоцитозі збудників хронічних інфекцій і продуктів клітинного розпаду. Зернистість в цитоплазмі (наявність гранул) відносить нейтрофіли до гранулоцитам і в цю групу, крім них, входять базофіли і еозинофіли .

Крім основної функції - фагоцитозу, де нейтрофіли виступають в якості вбивць, ці клітини в організмі мають і інші завдання: виконують цитотоксическую функцію, беруть участь в процесі згортання (сприяють утворенню фібрину), допомагають формуванню імунної відповіді на всіх рівнях імунітету (мають рецептори до імуноглобулінів Е і G, до лейкоцитарними антигенами класів А, В, С системи HLA, до інтерлейкіну, гістаміну, компонентам системи комплементу).
Як вони працюють?
Як було зазначено раніше, нейтрофилам властиві всі функціональні здатності фагоцитів:
- Хемотаксис (позитивний - покинувши кровоносну судину, нейтрофіли беруть курс «на ворога», «рішуче рухаючись в місце впровадження чужорідного об'єкта, негативний - рух направлено у зворотний бік);
- Адгезія (здатність зчіплюватися з чужорідним агентом);
- Уміння самостійно захоплювати бактеріальні клітини, не потребуючи в специфічних рецепторах;
- Здатність виконувати роль кілерів (вбивають захоплені мікроби);
- Перетравлювати чужорідні клітини ( «наївшись», нейтрофіл помітно збільшується в розмірі).
Відео: нейтрофіл бореться з бактерією
Зернистість нейтрофілів дає їм можливість (втім, як і іншим гранулоцитам) накопичувати велику кількість різних протеолітичних ферментів і бактерицидних факторів (лізоцим, катіонні білки, коллагеназа, міелоперексідаза, лактоферин і ін.), Які руйнують стінки бактеріальної клітини і «розправляються» з нею. Однак подібна активність може торкатися і клітини організму, в якому живе нейтрофіл, тобто, власні клітинні структури, вона їх пошкоджує. Це говорить про те, що нейтрофіли, інфільтруючи запальний осередок, одночасно з руйнуванням сторонніх чинників, своїми ферментами пошкоджують і тканини власного організму.
Завжди і всюди перші
Причини підвищення нейтрофілів не завжди пов'язані з якоюсь патологією. З огляду на те, що дані представники лейкоцитів завжди прагнуть бути першими, то вони будуть реагувати на будь-які зміни в організмі:
- Ситний обід;
- Інтенсивна праця;
- Позитивні і негативні емоції, стрес;
- Передменструальний період;
- Очікування дитини (при вагітності, у другій половині);
- Період розродження.
Такі ситуації, як правило, залишаються непоміченими, нейтрофіли підвищені трохи, а аналіз в такий момент ми не біжимо здавати.

Інша справа, коли людина відчуває, що занедужав і лейкоцити потрібні в якості діагностичного критерію. Нейтрофіли підвищені при наступних патологічних станах:
- Будь-які (які тільки можуть бути) запальні процеси;
- Злоякісні захворювання (гематологічні, солідні пухлини, метастази в кістковий мозок);
- Метаболічна інтоксикація (еклампсія при вагітності, цукровий діабет);
- Оперативні втручання в першу добу після операції (як реакція на травму), але високі нейтрофіли на наступний день після хірургічного лікування - нехороша ознака (це говорить про те, що приєдналася інфекція);
- Трансфузии.
Слід зауважити, що при деяких захворюваннях відсутність очікуваного лейкоцитозу (або ще гірше - нейтрофіли знижені) відносять до несприятливих «прикметами», наприклад, нормальний рівень гранулоцитів при гострій пневмонії не дає обнадійливих перспектив.
В яких випадках кількість нейтрофілів знижується?
причини нейтропенії теж досить різноманітні, однак слід мати на увазі: йдеться про знижених значеннях, викликаних іншою патологією або впливом деяких лікувальних заходів, або реально низьких цифрах, що може говорити про важкі захворювання крові (пригнічення кровотворення). Безпричинна нейтропенія завжди вимагає обстеження і тоді, можливо, причини знайдуться. Це можуть бути:
- Температура тіла вище 38 ° С (відповідна реакція на інфекцію загальмовується, рівень нейтрофілів падає);
- Захворювання крові (апластична анемія );
Велика необхідність в нейтрофілах при важких інфекційних процесах (черевний тиф, бруцельоз); - Інфекція при пригніченою продукції зернистих лейкоцитів в кістковому мозку (у ослаблених хворих або страждають на алкоголізм);
- Лікування цитостатиками, застосування променевої терапії;
- Лікарська нейтропенія (нестероїдні протизапальні препарати - НПЗП, деякі діуретики, антидепресанти та ін.)
- Колагенози (ревматоїдний артрит, системна червона вовчанка );
- Сенсибілізація лейкоцитарним антигенами (високий титр лейкоцитарних антитіл);
- Віремія (кір, краснуха, грип);
- Вірусний гепатит, ВІЛ;
- Генералізована інфекція (сепсис) - нейтропенія вказує на важкий перебіг і несприятливий прогноз;
- Реакція гіперчутливості (колапс, гемоліз);
- Ендокринна патологія (порушення функції щитовидної залози);
- Підвищений радіаційний фон;
- Вплив токсичних хімічних речовин.
Найчастіше причинами знижених нейтрофілів є грибкові, вірусні (особливо) і бактеріальні інфекції, а на тлі низького рівня нейтрофільних лейкоцитів добре себе почувають всі бактерії, що заселяють шкірні покриви і проникаючі в слизові верхніх дихальних шляхів, шлунково-кишкового тракту - замкнуте коло.
Інший раз самі зернисті лейкоцити є причиною імунологічних реакцій. Наприклад, в окремих випадках (при вагітності) організм жінки в гранулоцитах дитини бачить щось «чуже» і, намагаючись його позбутися, починає виробляти антитіла, спрямовані на ці клітини. Така поведінка імунної системи матері може негативно позначитися на здоров'ї новонародженого. Нейтрофільні лейкоцити в аналізі крові дитини будуть знижені, а лікарям доведеться пояснювати мамі, що таке ізоімунна неонатальна нейтропенія.
аномалії нейтрофілів
Щоб зрозуміти, чому нейтрофіли так поводяться в тих чи інших ситуаціях, слід краще вивчити не тільки характеристики, властиві здоровим клітинам, але і познайомитися з їх патологічними станами, коли клітина змушена переживати незвичайні для себе умови або нездатна нормально функціонувати через спадкових, генетично обумовлених дефектів:
Придбані аномалії і вроджені дефекти нейтрофілів не кращим чином позначаються на функціональних можливостях клітин і на здоров'я пацієнта, в крові якого виявлено неповноцінні лейкоцити. Порушення хемотаксису (синдром ледачих лейкоцитів), активності ферментів в самому нейтрофілів, відсутність реакції з боку клітини на поданий сигнал (дефект рецепторів) - всі ці обставини помітно знижують захисні сили організму. Клітини, які повинні бути першими у вогнищі запалення, самі «хворіють», тому не знають, що їх чекають або не можуть виконати покладені на них завдання, навіть якщо в такому стані прибудуть на місце «аварії». Ось такі вони важливі - нейтрофіли.
Як вони працюють?В яких випадках кількість нейтрофілів знижується?